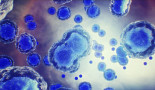
메조블라스트, ‘설립 20년만’ MSC 줄기세포 “美 첫승인”

검색
검색어를 입력하세요.
-
셀트리온, 1000억 규모 자사주 "추가 취득 결의"
정지윤 기자 2024-12-27 13:54
-
우시앱텍, 美투자사에 ‘세포·유전자치료제부문’ 매각
신창민 기자 2024-12-27 11:52
-
셀트리온, '다잘렉스 시밀러' 3상 "美 IND 승인"
정지윤 기자 2024-12-27 10:53
-
BMS, TYK2저해제 '소틱투' 건선성관절염 3상 "성공"
정지윤 기자 2024-12-27 09:55
-
랩트 "실패후 탈바꿈", 中서 '반감기↑IgE' 7억弗 딜
김성민 기자 2024-12-27 07:02
-
아이오니스, ‘큰 기대’ ASO 희귀고지혈증 “美 첫승인”
신창민 기자 2024-12-26 12:44
-
갈렉틴, '갈렉틴-3 저해제' MASH 3상 "실패"
정지윤 기자 2024-12-26 11:30
-
임종윤, 한미사이언스 5% 매각.."경영권분쟁 종결"
김성민 기자 2024-12-26 10:46
-
큐로셀, ‘안발셀’ 식약처 "개발단계 희귀의약품 지정"
김성민 기자 2024-12-26 09:25
-
루닛, 응급실 'AI 활용' 응급환자 분류시간 "77% 단축"
김성민 기자 2024-12-26 08:58
-
알테오젠, '아일리아 고용량' 제형특허 우선권 특허출원
김성민 기자 2024-12-26 08:45
-
NGM 'VC 피인수 10개월만', 첫 라이선스딜 체결 "활로"
김성민 기자 2024-12-26 07:11
-
한미약품, 저용량 고혈압 3제복합제 "국내허가 신청"
김성민 기자 2024-12-24 14:21
-
뷰노, 237억 규모 '영구 CB 발행' 결정
신창민 기자 2024-12-24 13:57
-
메조블라스트, ‘설립 20년만’ MSC 줄기세포 “美 첫승인”
신창민 기자 2024-12-24 13:45